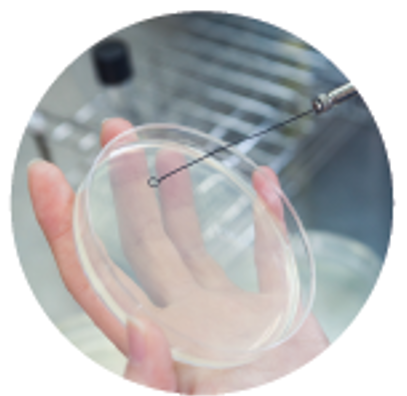

연구
열린 미래 꿈이있는 대학, 동아대학교
연구
Research interests
- Bioremediation
- Site characterization and environmental forensics
- Anaerobic wastewater treatment and energy production
- Molecular microbial ecology
Ongoing projects
- Biological improvement of water quality in Managed Aquifer Recharge (MAR) technology
- Microbial removal of perchlorate and nitrate:
- Continuous reactor development
- Qualitative & quantitative characterization of perchlorate-reducing bacteria (PRB) and denitrifiers
- Characterization of indigenous microorganisms involved in natural attenuation of perchlorate
- Characterization of biofilm microbial-community in perchlorate & nitrate removal process